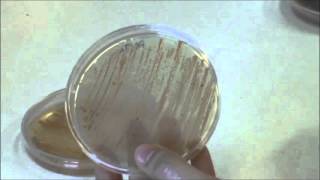
Técnicas básicas de Microbiología: Aspecto de bacterias del género Micromonospora.

Download Lagu MP3 & Video: Tipos De Bacterias Morfologico Basico Ilustracion Del
THE SHAPE OF BACTERIA | BACTERIAL MORPHOLOGY | MICROBIOLOGY | BACTERIAL CLASSIFICATION
Química Verap - 2 years ago
Download
¿Qué son las BACTERIAS? 🦠 | Definición, Características y Clasificación
EcologíaVerde - 1 year ago
Download
Generalidades de las Bacterias: Estructura, Reproducción y Morfología
Ilse Fiedler AGRO-BIO - 3 years ago
Download
Morfología bacteriana; forma, superficie y borde. Dra. Lourdes Echevarría 🔬
Lourdes Echevarria - 5 years ago
Download
Estructura de una bacteria facil y rapido l ESTRUCTURA BACTERIANA l estructura de las bacterias 2021
Química Verap - 5 years ago
Download
MORFOLOGIA BACTERIANA: descubre las formas bacterianas más extrañas del mundo
Profesor Doménech - 1 year ago
Download
Técnicas básicas de Microbiología: Aspecto de bacterias del género Micromonospora.
Área Microbiología Universidad de Salamanca - 10 years ago
Download







![🦠 ¿Qué son las Bacterias? 🦠 [Fácil y Rápido] | BIOLOGÍA | 🦠 ¿Qué son las Bacterias? 🦠 [Fácil y Rápido] | BIOLOGÍA |](https://i.ytimg.com/vi/U8NNW6Jkei8/mqdefault.jpg)